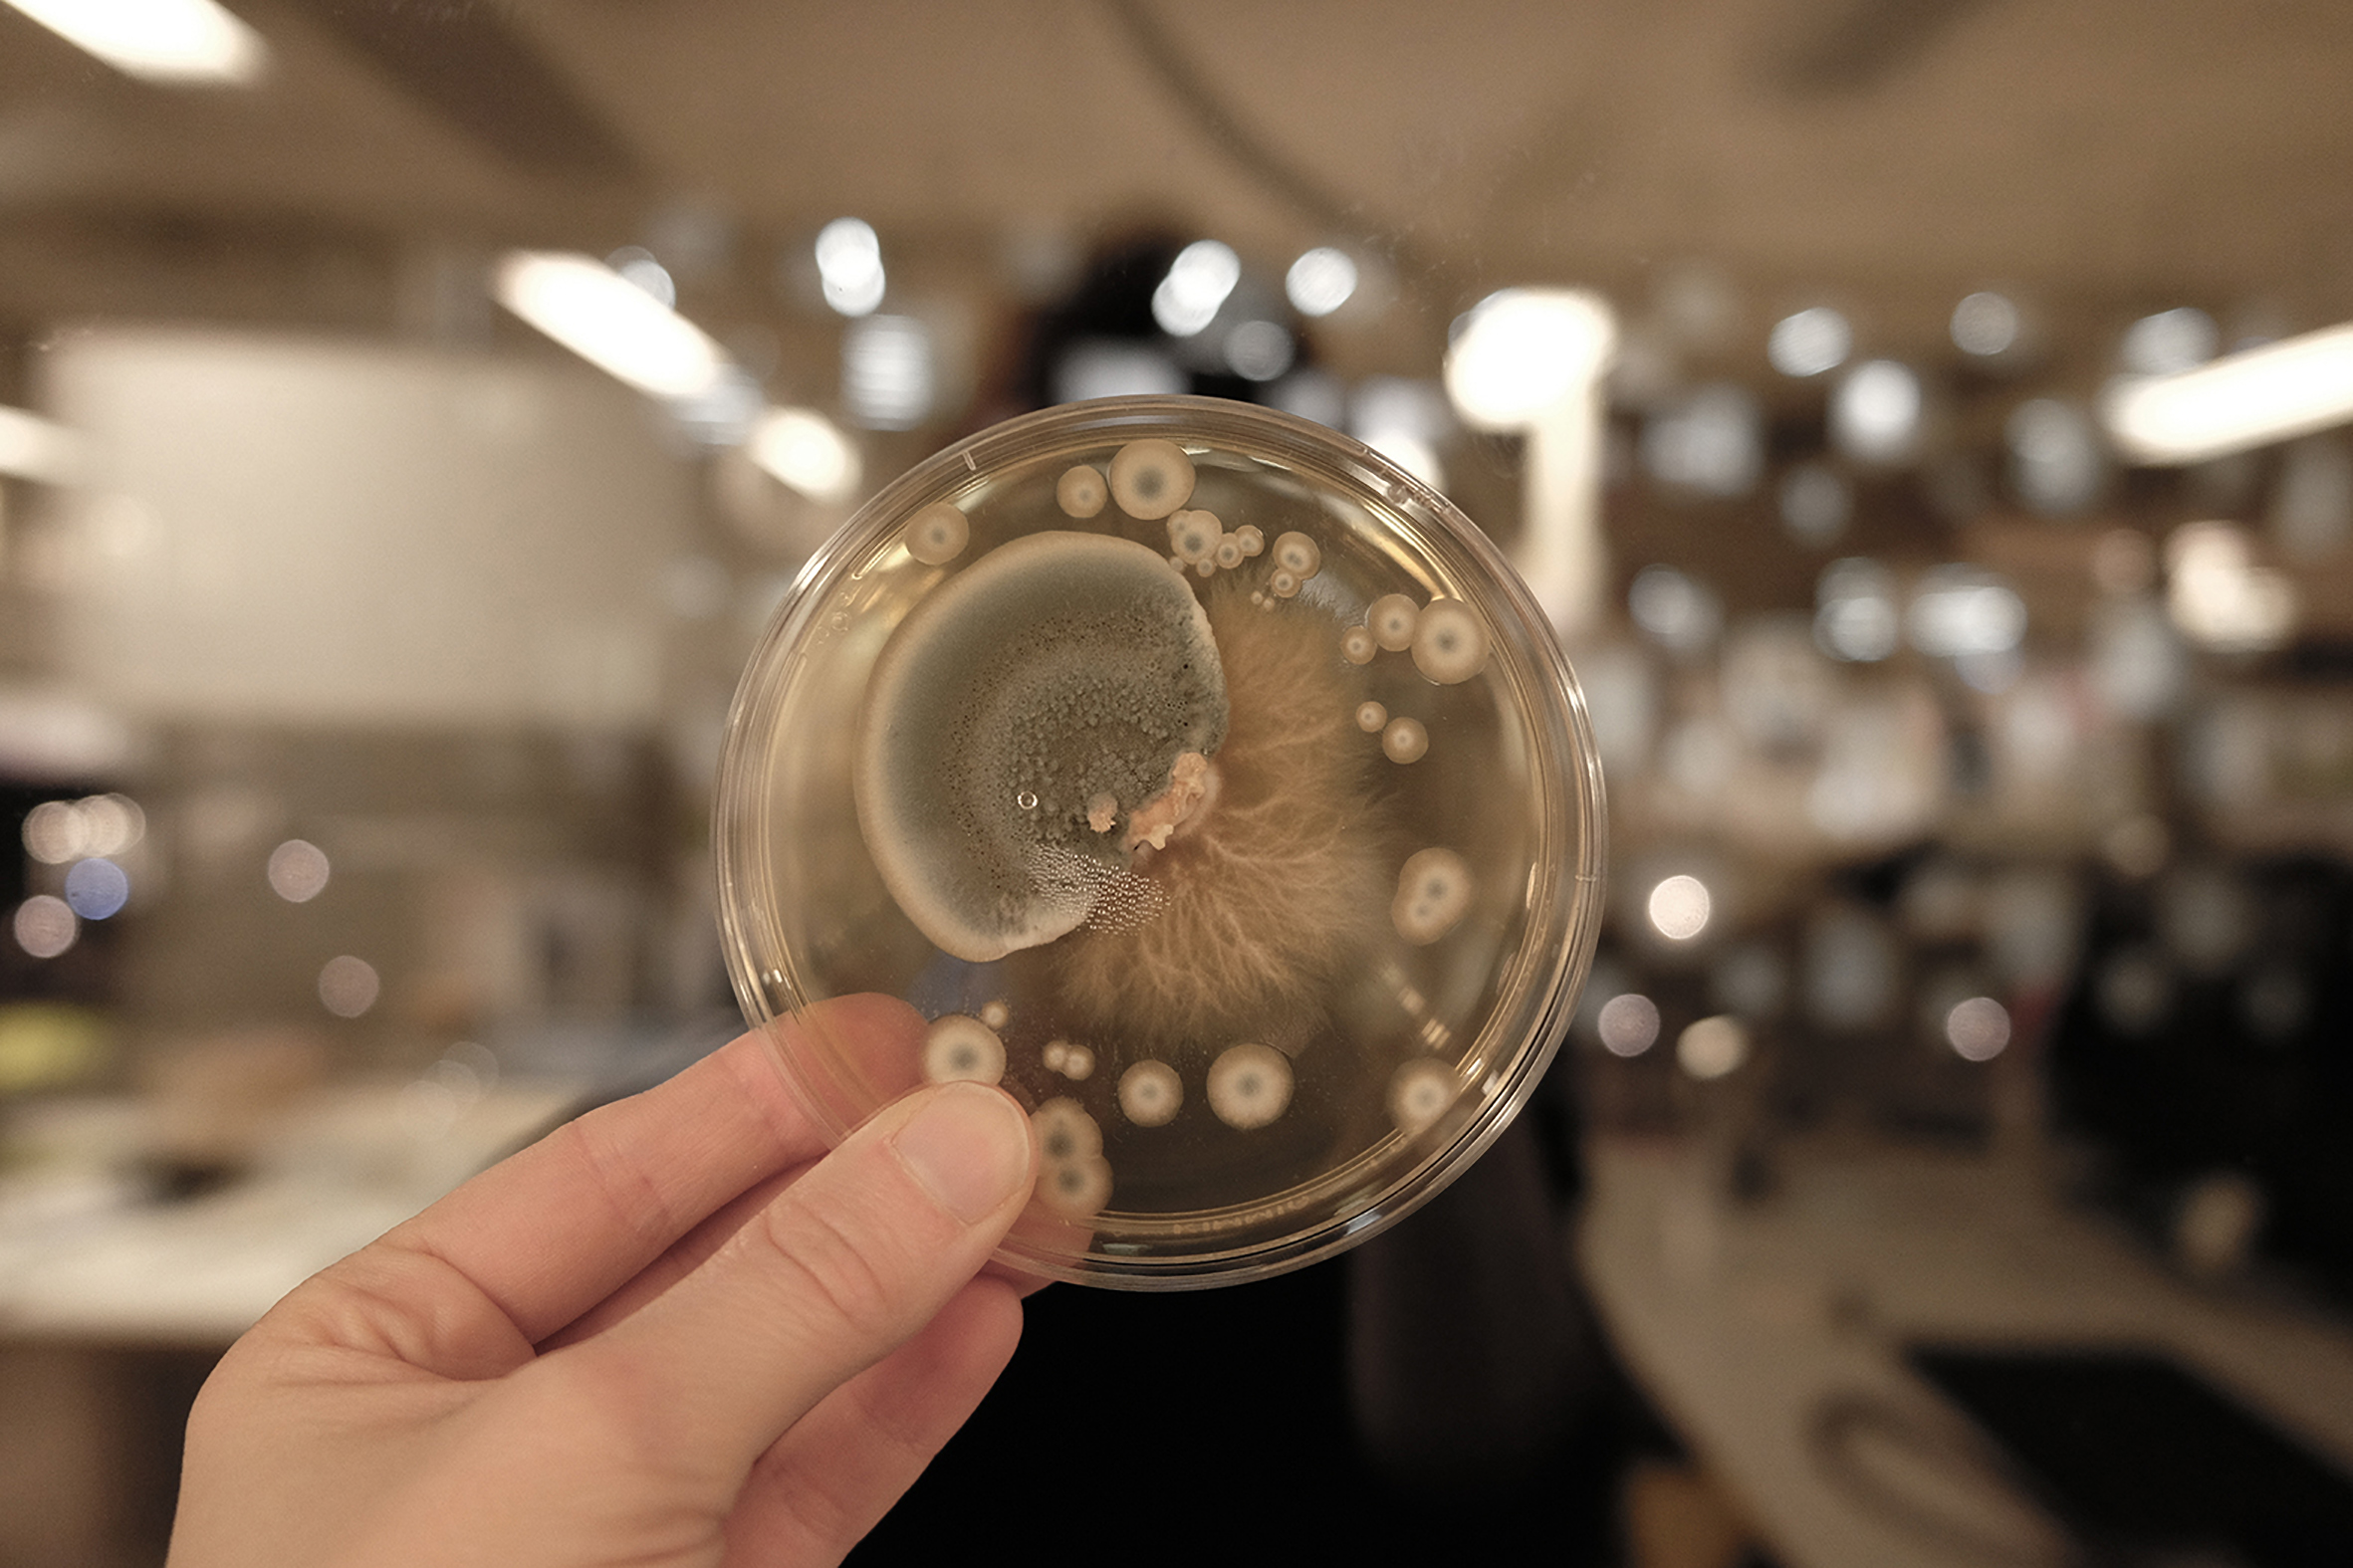
Cloning Cultures
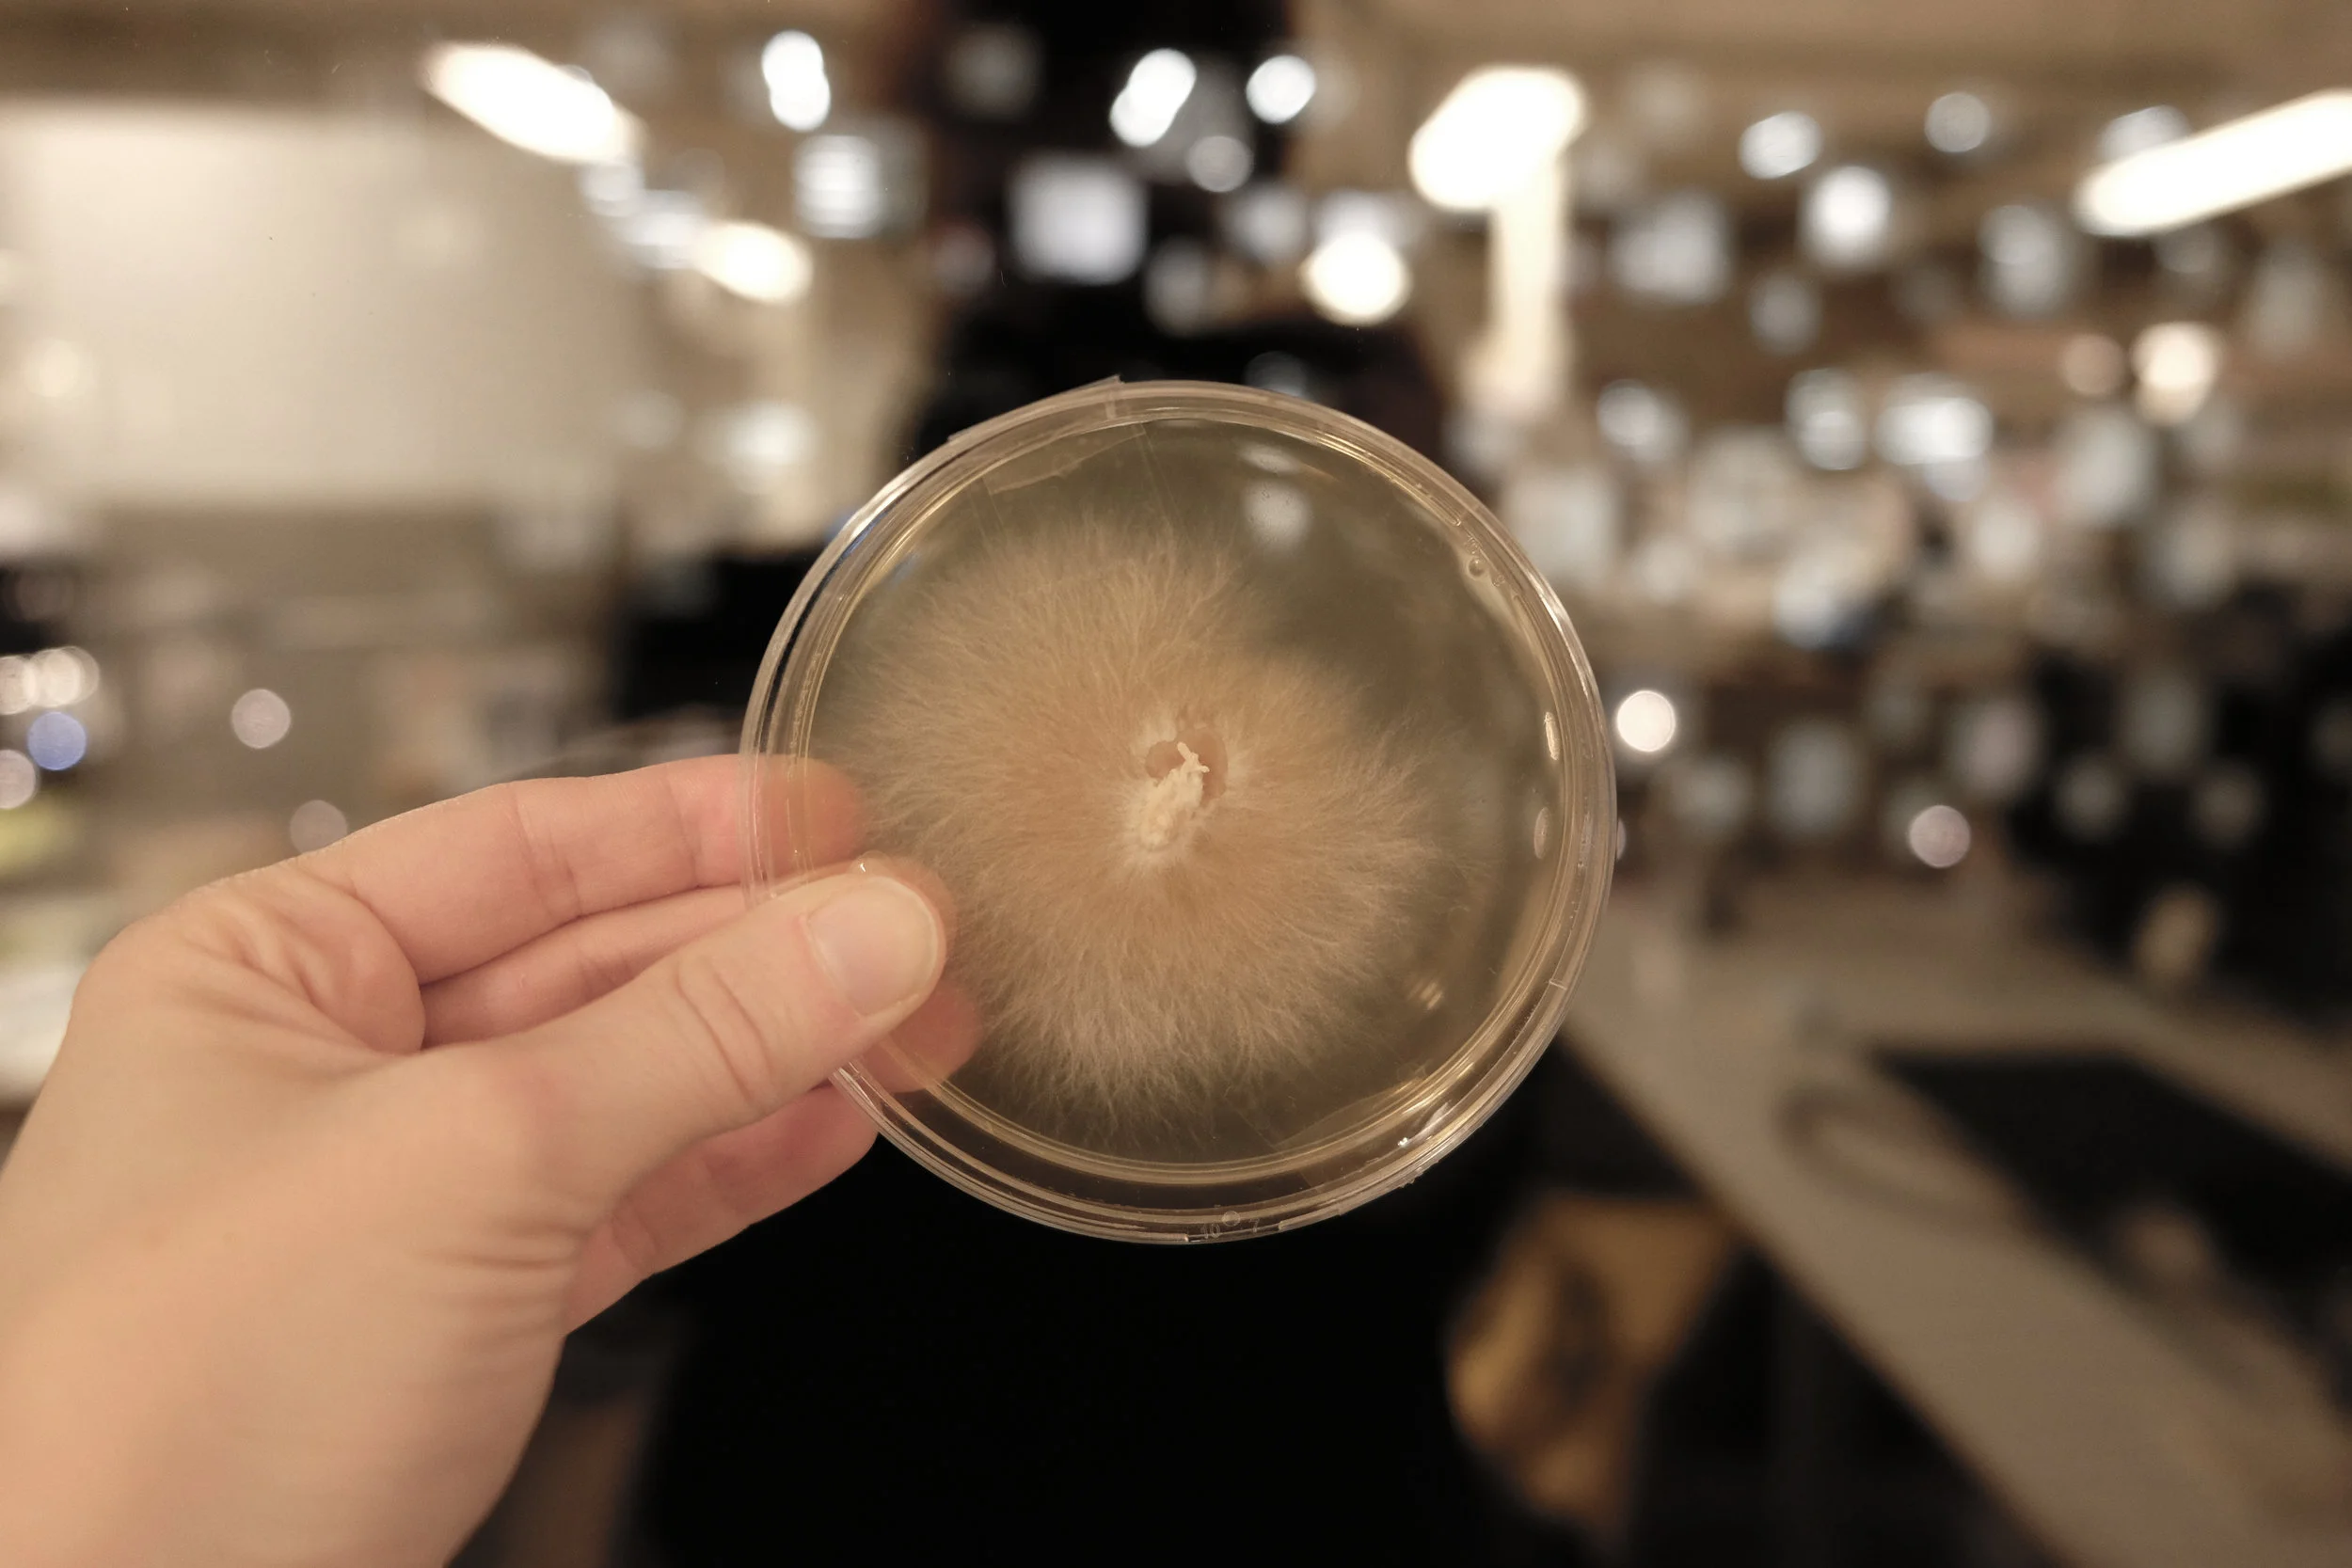
successful clone - mycelium only

my:celium


Superpower of Fungi
Fungus offer sustainable and Eco-friendly solutions for a lot of mankinds biggest problems of the future, like
_antibiotic resistance,
_the rise of mental diseases like depression,
_the need for sustainable material to replace plastic and
_harvesting more protein based food for a growing population.



Material of the future
Fungus is a sustainable alternative material for furniture, packaging and textiles, even fake leather can be made out of fungus.

Agriculture
Symbiotic mykorrhiza fungus can replace fertilizer and make plants climate change proof in an eco-friendly way. It is a rich source of protein and can help feeding a growing population.

Health Benefits
The biggest health challenges by 2030 will be depression, cancer, antimicrobial resistance and diabetes.
Many fungus have a great impact on the human body and mind, the active compound in hallucinogenic mushrooms can even cure mental illnesses like anxiety and depression.
Shiitake Lentinula edodes
anti-viral, anti-inflammatory, anti-tumorous effect, cures allergies, boosts immune defense

Status Quo - How to grow fungus
Growing and reproducing mushrooms in a controlled way is nearly impossible in a home environment. It requires a lot of experience and a laboratory like work space to succeed.

Journey Map

Process improvement
The fungi cultivation process requires a lot of equipment and takes a lot of time and effort. My goal is to simplify the process, to get rid of time consuming and boring tasks and eliminate all sources of errors. On the other side I want to maintain the most enjoyable steps along the journey that make the user feel like being in control.
Cloning Cultures
I learned how to to extract the pure mushroom culture (mycelium) to be able to reproduce the mushroom. The biggest challenge is to avoid contaminations - a sterile working is crucial!
Failed clone - mold contamination taking over the mycelium
The error rate when extracting a fungus culture is very high and that can lead to frustration.
successful clone - mycelium only



my:celium
The my:celium system provides you with the environment and tools that are needed to cultivate fungi. It introduces you to the kingdom of fungi in an easy and engaging way.
In the my:celium grow sphere you can grow delicious and healthy mushrooms - be part of a process that is usually hidden from the human eye by bringing the beauty of nature into your home.


Growing mushrooms with my:celium

Colonizing Phase
In the first stage of mushroom growth, the white fluffy mycelium hyphae is growing all over the substrate. Use a ready-to-grow my:celium bulb and put it for the colonizing phase into the lower grow sphere section.
It simulates the conditions for the underground mushroom growth:
_no daylight
_temp. 10 - 15 °C
_humidity 90%

Fruiting Phase
When the mycelium has infected all the substrate it will start to grow mushroom fruits. This happens in the upper section of the grow sphere. Move the grow bulb for the fruiting phase into the upper grow sphere section. Don’t worry - you will get a reminder from the my:celium app.
The top section of the grow sphere simulates forest conditions and allows different fungus species to grow along with each other.
_individual lightning
_temp. 20 - 22 °C
_humidity 90%



The pen station functions as culture incubator, archive and educational hub.

How cloning mushrooms works
With the my:celium clone pen, you can easily reproduce every kind of mushroom. You can collect and archive the extracted fungus cultures for future use.



